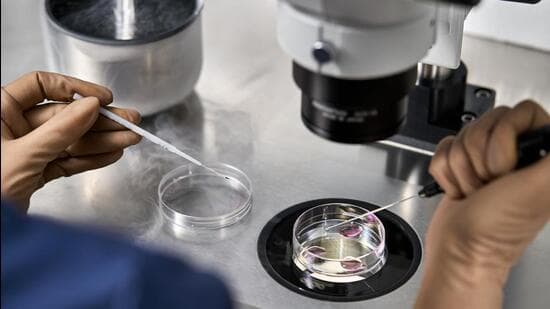
Court Orders IVF Clinic De-sealing for Embryo Preservation

Home / Crime and Justice / Court Orders IVF Clinic De-sealing for Embryo Preservation
Court Orders IVF Clinic De-sealing for Embryo Preservation
17 Mar
Summary
- Court ordered Nashik clinic de-sealed every fourth day for liquid nitrogen replacement.
- Clinic sealed over alleged illegal extraction and sale of human eggs.
- 35 frozen embryos at risk of destruction if liquid nitrogen is not replaced.

A division bench of justices Ravindra Ghuge and Abhay Mantri has mandated the Nashik Municipal Corporation (NMC) to partially de-seal the Malti IVF Centre every fourth day. This exceptional measure is to facilitate the replacement of liquid nitrogen essential for preserving 35 frozen embryos belonging to patients. The clinic was sealed on March 4, following the arrest of its director, Dr. Amol Patil, on suspicion of illegal extraction and sale of human eggs from vulnerable women. The police are investigating allegations of exploiting around 20 women as egg donors, violating the ART Act, 2021.
Dr. Vandana Patil, wife of the arrested director and a co-owner of the clinic, petitioned the high court. She challenged the NMC's sealing and de-registration order, arguing it was illegal as the initial FIR did not name the clinic or her husband. She highlighted that without regular liquid nitrogen replacement, the 35 embryos would be destroyed, jeopardizing patients' chances of having children. The court acknowledged the NMC's "gracious gesture" in agreeing to allow access for the crucial procedure.